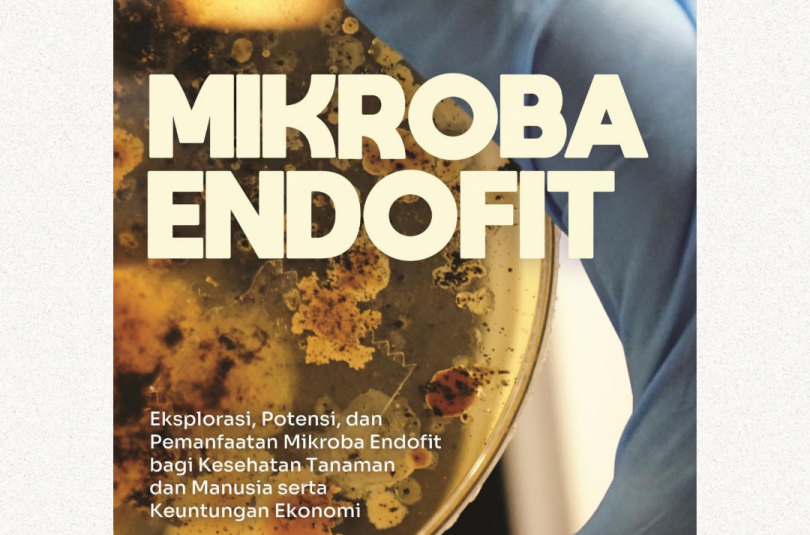
Mikroba Endofit

Buku ini membahas semua jenis penyakit tanaman kelapa karena fitoplasma, gangguan fisiologis, dan kahat hara. Setiap penyakit tanaman dibahas lengkap penyebabnya, klasifikasi, gejala penyakit kisaran tanaman inang, faktor yang sesuai, dan beragam upaya pengelolaan penyakit.
Author: Loekas Soesanto (Loekas Soesanto)
Sirih Cina; Herbal untuk Regenerasi Tulang dan Masalah Kesehatan
Tumbuhan sirih Cina mengandung sejumlah senyawa bioaktif yang bermanfaat bagi kesehatan manusia, di antaranya untuk regenerasi tulang, gula darah, ginjal, antiinflamasi, antioksidan, dan banyak lagi.
Bawang Merah
Buku ini menyajikan panduan budidaya bawang merah, mengenalkan hama, penyakit, dan gulma yang menyerang tanaman ini, serta gejala dan metode pencegahannya.
Rumput Mutiara; Herbal Antitumor dan AntiKanker
Buku ini membahas lengkap dengan permasalahan rumput mutiara, dari karakter morfologi dan budidayanya, karakter fisiologi dan persebarannya, serta karakter biokimia berserta manfaat dan teknologi praktisnya.
Pengelolaan Layu Fusarium secara Organik pada Melon Hidroponik
Pengendalian penyakit layu Fusarium pada tanaman melon hidroponik di dalam green house secara organik adalah dengan menggunakan metabolit sekunder mikroba antagonis.
Kompendium Penyakit-Penyakit Cabai
Buku ini memberikan informasi terlengkap dan terkini tentang semua jenis penyakit tanaman cabai, baik disebabkan oleh jamur, bakteri, virus, nematoda, kahat hara, dan penyebab lain
Kompendium Penyakit-Penyakit Kakao
Buku ini membahas lengkap dan akurat tentang semua jenis penyakit tanaman kakao, baik yang disebabkan jamur, bakteri, virus, penyebab lain
Kompendium Penyakit-Penyakit Pisang
Buku ini memberikan informasi semua penyakit tanaman pisang, baik di pembibitan, pertanaman, maupun pascapanen dibahas lengkap, dari penyebab penyakit, gejala penyakit, kisaran inang patogen, faktor yang berpengaruh, serta pengelolaan penyakit terpadu, baik penyakit tanaman pisang.
Pengantar Pengendalian Hayati Penyakit Tanaman
Buku ini memberikan pengertian yang cukup mendalam tentang pengendalian penyakit tanaman secara hayati.
Mikroba Endofit
Pengetahuan yang mendalam akan mikroba endofit semakin diperlukan untuk menunjang eksplorasi dan isolasi senyawa yang sangat berguna bagi kesehatan tanaman dan manusia dan mempunyai keuntungan secara ekonomi.